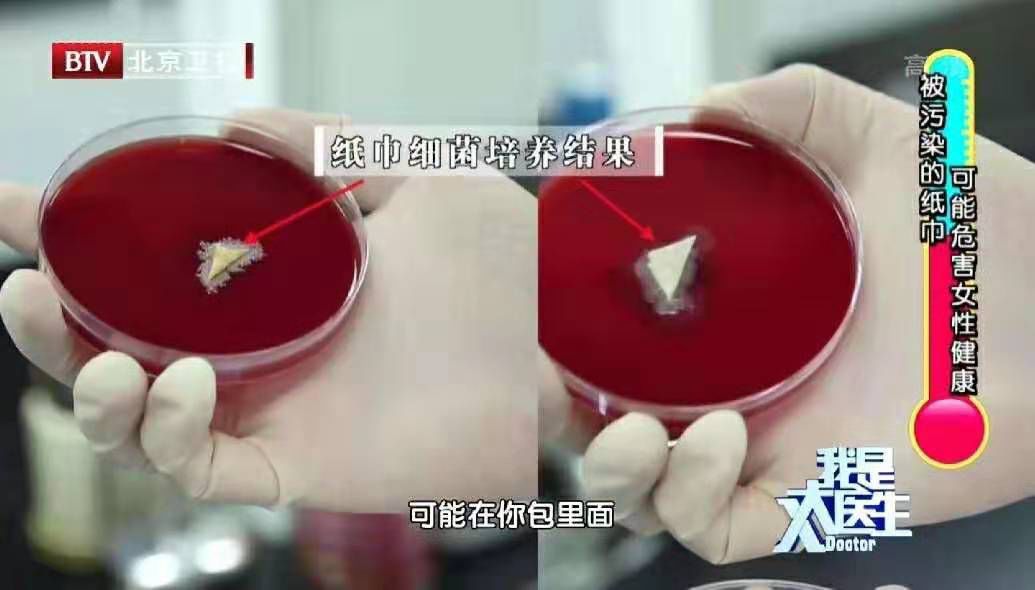
*生活性**后还在用纸巾「打扫战场」？看看医生是怎么说的

来源|医闻速递
对于情侣和夫妻来说,健康的*生活性**不仅使人身心愉悦,还能加深感情。
可筋疲力尽之后,相应的清洁问题要怎么办?
相信不少人为了图方便,选择使用卷纸擦拭!
但这其实是个坑,是种医生反对的卫生行为!
为什么这么说?
01
纸巾纸和卫生纸,傻傻分不清
你每天都在用纸,但你可能也没分清纸的区别。同样是生活用纸,抽纸就属于「纸巾纸」,而卷纸却是「卫生纸」,它们是有不同卫生标准的。

「卫生纸」就是我们的厕所用纸,比如各种卷纸,它的执行标准要求菌落总数应≤600cfu/g(mL)。
而「纸巾纸」,也就是我们常用的面巾纸、餐巾纸,它的执行标准更加严格,要求菌落数应≤200cfu/g(mL)。
(cfu就是菌落形成数。也不用弄明白这个单位,反正记住纸巾纸比卫生纸干净就行)
不知你们用来擦洗的到底是什么纸?
02
选择纸巾就是选择了面对风险
卫生纸和纸巾是生活必需品,因此品牌繁多。这么多的品牌,其中就混杂着不少假冒伪劣产品。即使你到正规商场购买,也不能保证买到「合格」的纸巾。
7月份央视就曾报道,江苏市场监管局质检的150批次纸巾中,就有多达36批次的纸巾产品不合格,其中9批次的细菌菌落数超过国家标准13倍。

检测结果显示,这些「不卫生」的卫生纸问题多出在原料上,大多都是违规使用废纸原料或非木纤维原料。
这几年卫生纸问题被频繁揭露,主要的问题集中在:违规使用废纸原料;大量添加工业滑石粉;毫无保障的生产环境。
除此之外,你可能还会遇到真假美猴王的问题。

你仔细看看,它们是同一种纸巾吗?
*生活性**后用纸巾擦洗,你就有可能踩到这些纸的坑。真菌、绿脓杆菌、大肠杆菌等细菌可能就会趁机而入,诱发生殖系统炎症。
03
干净的纸巾放久了就不干净了
再干净的纸巾,只要开了封,就避免不了接触外界,这就给细菌滋生创造了机会。尤其是放在口袋、包包这些细菌超标的地方。可能仅仅几个小时,细菌会布满这些纸巾。
有媒体曾做过这样的实验,抽取两名工作人员放在包里的纸巾进行细菌培养,2天之后,两份样品无一例外都长满了细菌。
由于女性生殖道和尿道较短,极容易受到细菌感染。
一旦身体体抗力下降,这种平时埋下的「祸根」可能一下子就被引爆,从而引发外阴炎、阴道炎、膀胱炎等妇科疾病和泌尿系感染。
04
消毒纸巾其实并不合格
湿纸巾比其他纸巾卫生,而且还有杀菌物质,是不是就适合用来擦洗呢?
湿纸巾除了杀菌物质,还存在其他化学溶剂,用在*处私**会对皮肤造成刺激反应,不适合在房事后用来擦拭。
而对于那些有会阴损伤或过敏体质的人群,还可能引起外阴瘙痒和阴道炎。
而且人体生殖系统结构很复杂,尤其是女性,其*处私**皮肤有较多较深的褶皱。
一旦用了湿纸巾,就会使*处私**变得更加潮湿。持续潮湿的局部环境容易成为细菌繁殖的温床,从而引发各种细菌感染。
05
不管什么纸巾都不能代替清洗
*生活性**后,各种分泌物都附着在外生殖器上,尤其是女性的会阴处和男性阴囊部。而单纯用纸擦洗,并不能彻底清掉这些,会给细菌的繁殖提供有利条件。
而且,纸巾是一种易溶于水,非常容易被水分解的物品。
不同的纸,它的韧性和吸水能力也不太一样。擦屁屁的「卫生纸」就比擦嘴的「纸巾纸」吸水能力更好,但吸水后韧性就会变得很差。

假如你在*生活性**后拿「卫生纸」来擦洗*处私**,可能会出现这样一种情况:会阴粘上许多纸巾碎屑。
一旦这些纸屑碎片没有清理干净,就有很大可能诱发炎症性病变。
其实,为爱鼓掌之后只要花几分钟就能用水清洗干净。千万不要因为贪恋一时的温存而害了自己。
赶快转发给你的ta,一起学习这些关于为爱鼓掌的小知识!
来源丨医闻速递
作者丨医护多团队
